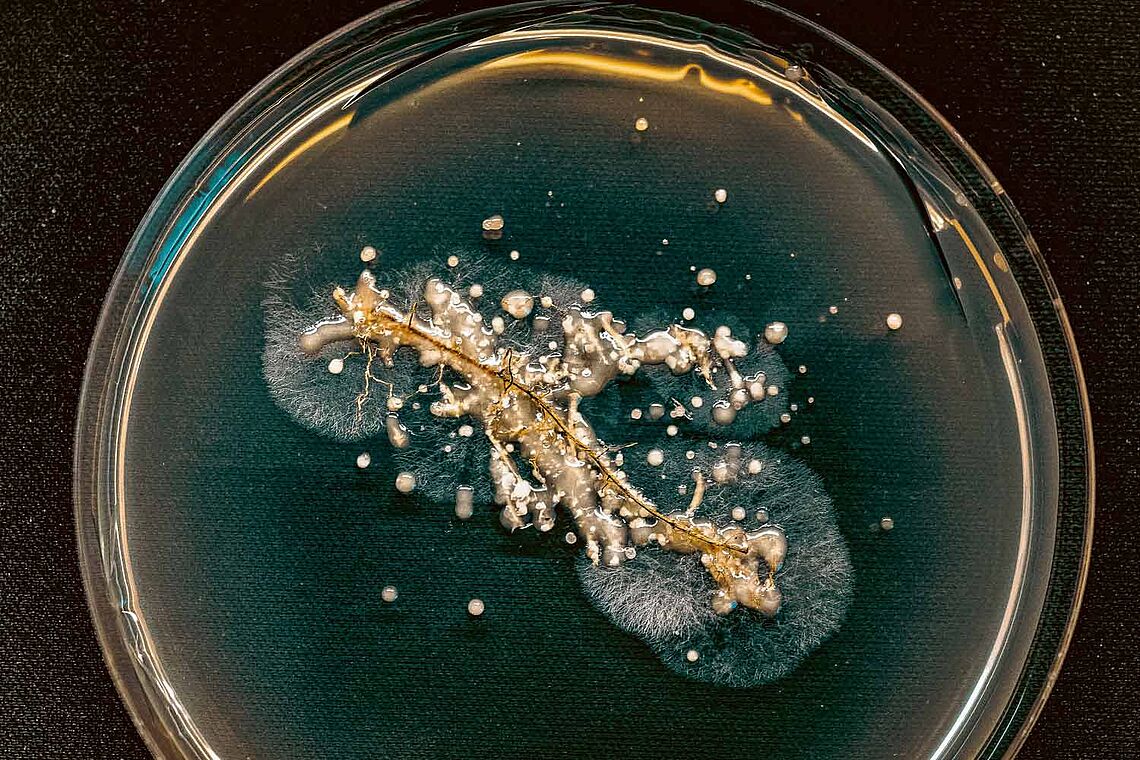
Sind „Schwammerl“ das neue Hightech?

Hauptinhalt
Idee: MyPilz
Sind „Schwammerl“ das neue Hightech?
Computerspeicher aus Shiitakepilzen? Als diese Meldung Mitte Dezember auf „ORF Science“ erschien, hielten sie viele wohl für einen sehr frühen Aprilscherz. Dennoch war es einem US-Forschungsteam gelungen, aus dem Myzel des beliebten Speisepilzes einen elektrischen Widerstand mit Speicherfunktion herzustellen, der ganz ohne seltene Erden auskommt, hohe Strahlenbelastung aushält und das Gespeicherte sogar behält, wenn er zwischendurch einmal austrocknen sollte.
In Zukunft könnten Pilze aber nicht nur als Computerspeicher zum Einsatz kommen. Aufgrund ihrer besonderen Eigenschaften werden sie zunehmend als universelle Problemlöser für die großen Herausforderungen unserer Zeit entdeckt.
Jetzt weiterlesen
Sie haben bereits ein GEWINN-Abo?
Sichern Sie sich jetzt Ihr Angebot und lesen Sie weiter
Zu den Angeboten


